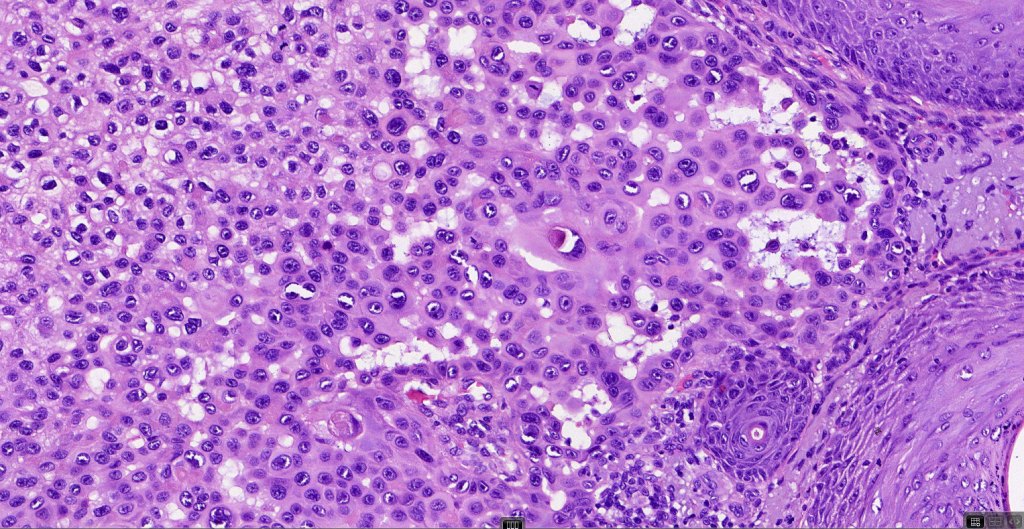
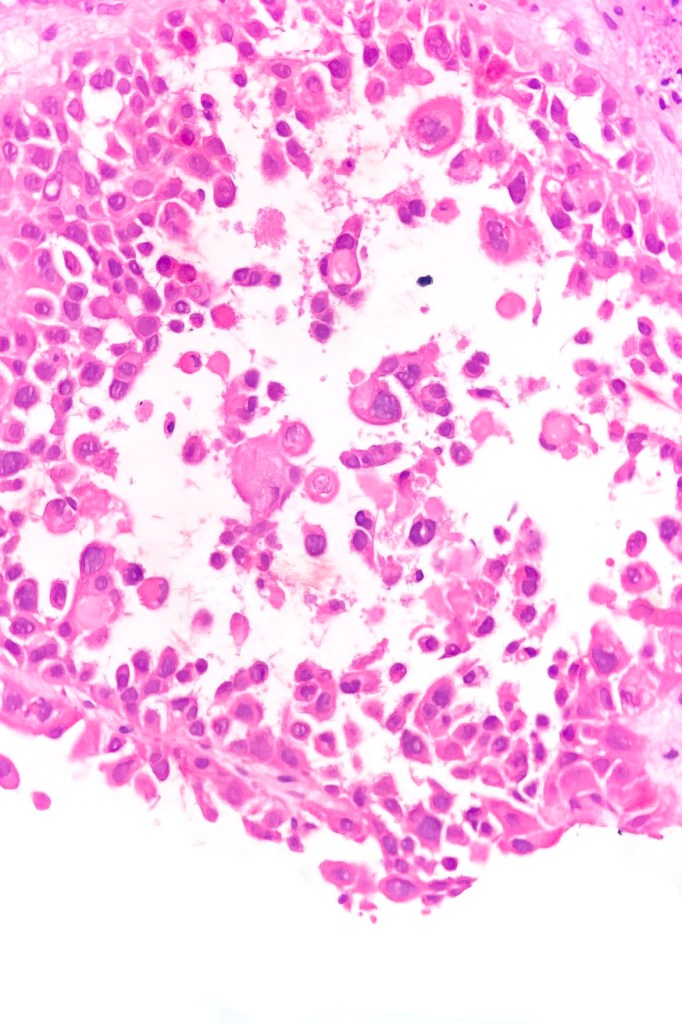

Clinical features
•This variant shows a predilection for the head & neck of the elderly; less often on the limbs, genitalia & elsewhere
•Sometimes arises in an acantholytic actinic keratosis
•Presents as a frequently ulcerated nodule or plaque
•Intraoral variant
•Although previously thought to represent an aggressive variant of SCC with high recurrence and metastasis rate, this is has largely been disproven
Histological features
•Acantholysis gives rise to a pseudoglandular appearance
•Often well differentiated
•Variable pleomorphism & mitotic activity
•May be folliculocentric rather than arise from the epidermis
•Associated sweat gland atypia sometimes present in the deeper reaches
•Amyloid may be present
•Exceptional associated signet-ring cell change (signet ring cell squamous carcinoma)
•Absence of epithelial mucin
•EMA+ve, CEA-ve
. CK7, DPAS, mucicarcmine & alcain blue-ve

Differential diagnosis
In my experience, acantholytic squamous carcinoma invariably shows foci of more obvious squamous differentiation but if this is not the case, then an adenocarcinoma (particularly metastatic) enters the differential diagnosis. Demonstration of CK7 or CK20, CEA, DPAS, mucicarmine or alcain blue should readily afford their distinction. Exceptionally, melanoma can show a pseudoacantholytic (pseudoglandular) appearance due to excessive stromal mucin deposition.




Leave a comment